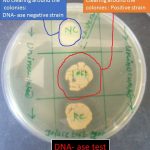
DNase test

Collection Group: Clinical Bacteriology
Hydrogen Sulfide Production by Various Organisms and Its Detection Methods
 Hydrogen Sulfide Production by Various Organisms Hydrogen sulfide production by various...
Hydrogen Sulfide Production by Various Organisms Hydrogen sulfide production by various...
H2S Positive Bacteria: Introduction, List, Detecting Tests and Media Used
 Introduction of H2S Positive Bacteria H2S positive bacteria Proteus vulgaris...
Introduction of H2S Positive Bacteria H2S positive bacteria Proteus vulgaris...
DNase Test for Bacteria: Introduction, Principle, Procedure, Result Interpretations and Limitations
Introduction of DNase Test for Bacteria DNase tests positive and...
Introduction of DNase Test for Bacteria DNase tests positive and...
